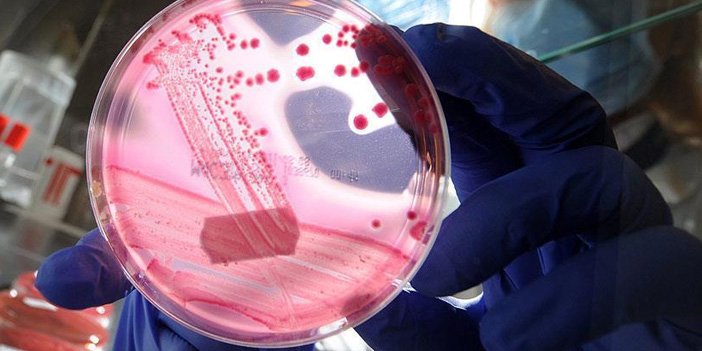
kanser evresi nasıl tespit edilir

Kanser teşhisi nasıl belli olur? Kanser evresi nasıl tespit edilir?
Günümüzde en çok ölüme sebep olan hastalıklardan biri kanser olarak biliniyor. Bu herkes tarafından bilinen bir gerçektir. Ancak önceden konulmuş teşhis hayat kurtarabiliyor. Peki, Kanser teşhisi nasıl belli olur? Kanser evresi nasıl tespit edilir?
Kanser dünya genelinde en sık ölüme neden olan hastalıklar arasında ikinci sırada yer alıyor. Verilere göre; dünyada yaklaşık her 6 ölümden biri, ülkemizde de her 5 ölümden biri kanser nedeniyle gerçekleşiyor. Dünya Sağlık Örgütü 2020 yılı verilerine göre; dünya genelinde her yıl yaklaşık 19,3 milyon insan kanser teşhisi alıyor ve yaklaşık 10 milyon kişi de bu hastalıktan vefat ediyor. Ancak önceden konulmuş bir teşhis hayat kurtarıyor. Erken teşhisin öneminden bahseden Tıbbi Onkoloji Uzmanı Dr. Mustafa Bozkurt, kanser hastalığının belirtilerinden bahsederken insanlara uyarılar yaptı. Peki, Kanser teşhisi nasıl belli olur? Kanser evresi nasıl tespit edilir? İşte tüm detaylar:

KANSER TEŞHİSİ NASIL BELLİ OLUR?
Acıbadem Üniversitesi Atakent Hastanesi Tıbbi Onkoloji Uzmanı Dr. Mustafa Bozkurt, erken teşhis edilmesi için kanser hastalığının erken dönem belirtilerini bilmenin ve zaman kaybetmeden doktora müracaat etmenin önemli olduğuna dikkat çekerek, “Ancak insanlar yakınmaları olduğunda ‘kötü bir şey çıkacak’ kaygısıyla sağlık kuruluşuna başvurmayı hep öteliyorlar. Oysa erken teşhis sayesinde artık pek çok kanser türü tedavi edilebiliyor, hatta tam şifa sağlanabiliyor. Dolayısıyla korkuları bir kenara bırakmak ve hiçbir yakınma olmasa dahi kanser taramaları dâhil düzenli sağlık kontrolleri yaptırmak yaşam kurtarıyor” dedi. Tıbbi Onkoloji Uzmanı Dr. Mustafa Bozkurt, kanserin bazı erken belirtilerini anlattı; önemli uyarılar yaptı!

İSTEM DIŞI KİLO KAYBI
Kanser hücreleri, kontrolsüz çoğalan ve orantısız büyüyen bir yapı olarak, etkiledikleri dokunun damar yapısını kendi lehine dönüştüren maddeler salgılayarak besin ve oksijeni orantısız olarak yüksek seviyede alıyor. Ayrıca, metabolizmayı kendi lehine yöneten ve iştah kaybı kaybına yol açan maddeler salgılıyor. Dolayısıyla istem dışı kilo kaybı, iştahsızlık ve eşlik eden halsizlik ile yorgunluk kanserin erken sinyali olabiliyor.

GEÇMEYEN AĞRI
Tüm dünyada insanların en sık yakındıkları sorun ağrı oluyor, dolayısıyla her ağrı kansere işaret etmiyor. Ancak istirahat halinde geçmeyen ağrı, ağrılı bir meme kitlesi ya da dışkıda kan ve karın ağrısı birlikteliği, erken teşhis için sağlık kuruluşuna başvuruyu gerektiriyor.
ANORMAL KANAMALAR
İdrarda kanama, menopoz sonrası kanama, pek çok kişi tarafından basur kanaması olarak geçiştirilen dışkıda kanama veya kadınlarda cinsel ilişki sonrası kanama, karın alt bölgesi organlarına yönelik kanserin erken sinyalleri arasında yer alıyor.

TUVALET ALIŞKANLIĞINDA DEĞİŞİKLİK
Büyük tuvalet alışkanlığında kabızlık ve ishal yönünde beklenmedik değişiklik bağırsak kanserinden kaynaklanabiliyor. Zira bağırsakta gelişen kötü huylu tümör, dışkının bağırsaktan geçişini zorlaştıran kabızlığa yol açıyor. Bazı durumlarda ise darlık noktasının arkasında yığılan dışkı bağırsak bakterilerinin etkisiyle yumuşuyor ve bu kez ishal tablosu gelişiyor. Dr. Mustafa Bozkurt, “Düzenli bağırsak alışkanlığında beklenmedik kabızlık veya ishal gelişirse sağlık kuruluşuna başvurmak çok önemlidir” diyor.
SIRTA VURAN ÖKSÜRÜK
Öksürüğün özellikle kış ve bahar aylarında en yaygın görülen nedenleri viral enfeksiyonlar ile mevsimsel alerjiler oluyor. Ayrıca sigara içen kişilerde kronik öksürük de yaygın görülüyor. Ancak öksürük aynı zamanda bazı ciddi hastalıkların da erken belirtisi olabiliyor, örneğin akciğer kanseri gibi! Sırta vuran öksürük, daha da önemlisi kanlı öksürük, zaman kaybetmeden hekime başvuruyu gerektiriyor.
BENLERDEKİ DEĞİŞİMLER
Özellikle açık tenli kişilerin, benlerini ara ara fotoğraflayarak, şekil değişikliği açısından izlemeleri, en saldırgan cilt kanseri türü olan melanomun erken teşhisi için çok önemli. Bu nedenle vücutta yeni bir ben oluştuysa ya da var olan bir ben renk ve şekil değiştiriyorsa, kaşıntılı ve/veya kanamalı bir durum geliştirmişse, hekime başvurmakta acele etmek gerekiyor.
YUTMA GÜÇLÜĞÜ VE AĞRI
Yiyecekleri ve özellikle çayı normalden daha sıcak yeme-içme alışkanlığına sahip kişilerde yemeğin takılması ile yutma güçlüğü şeklindeki yakınmalar, yemek borusu kanserine işaret edebiliyor. Dr. Mustafa Bozkurt, “Zira, kötü huylu tümör varlığında yutulmaya başlanan yiyeceklerin veya içeceklerin boğaza, ardından yemek borusuna taşınmaları zorlaşabiliyor. Bunun sonucunda yutma güçlüğü ile ağrı yakınmaları gelişebiliyor” uyarısında bulunuyor.

İŞTAH KAYBI
Pek çok hastalığın belirtisi olan iştah kaybı da kanser için erken uyarı sinyali olarak karşımıza çıkabiliyor. Uzamış iştah kaybı tüm kanserler için bir uyarı olabilirken, özellikle baharatlı yemek kültürünün yaygın olduğu Güneydoğu Anadolu bölgesi gibi yörelerde, alışılmadık şekilde çabuk doyma veya yemek yiyememe mide kanserinin erken habercisi olabiliyor.
SIK SIK HASTA OLMAK
Kanser hastalığı bağışıklık sistemini zayıflatarak kolay hasta olmanın önünü açabiliyor. Ayrıca yine aynı nedenle iyileşmeyi de güçleştiriyor. Bu durum lösemi ve lenfoma gibi kan ve lenf sistemi kanserlerinde öne çıkıyor. Dolayısıyla genel olarak sık ve uzun süren ateşli hastalık ileri incelemeyi gerektiriyor.
CİLTTE İYİLEŞMEYEN YARALAR
Mesleği gereği veya bronzlaşmak uğruna güneş altında uzun saatler kalan kişilerin dudaklarında, saçlı derileri ile yüz cildinde çıkan ve iyileşmeyen yarayı cilt kanseri açısından önemsemeleri büyük önem taşıyor.
Haber Merkezi / www.gazeteilksayfa.com
Türkçe karakter kullanılmayan ve büyük harflerle yazılmış yorumlar onaylanmamaktadır.